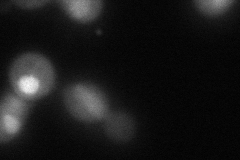

View description
Ribonucleotide-diphosphate reductase (RNR), small subunit; the RNR complex catalyzes the rate-limiting step in dNTP synthesis and is regulated by DNA replication and DNA damage checkpoint pathways via localization of the small subunits
Localization:
Intensity:
Fold change:
Significance:
-
C’ GFP library in SD

below threshold17.37 -
N' NOP1pr-GFP in SD

cytosol,nucleus,nucleolus546.522 -
N' TEF2pr-mCherry in SD

vacuole579.104 -
N' NATIVEpr-GFP in SD

punctate,nucleus142.091 -
N' TEF2pr-VC and Cyto-VN in SD
nucleus94.8512 -
C’ GFP library in SD+DTT

cytosol17.451No -
C’ GFP library in SD+H2O2

cytosol18.021.03No -
C’ GFP library in Starvation Media

cytosol29.891.71No -
C’ GFP library on the background of Pup2-DaMP

below threshold -
C’ GFP library on the background of CCT mutant

below threshold19.23641.10665No
